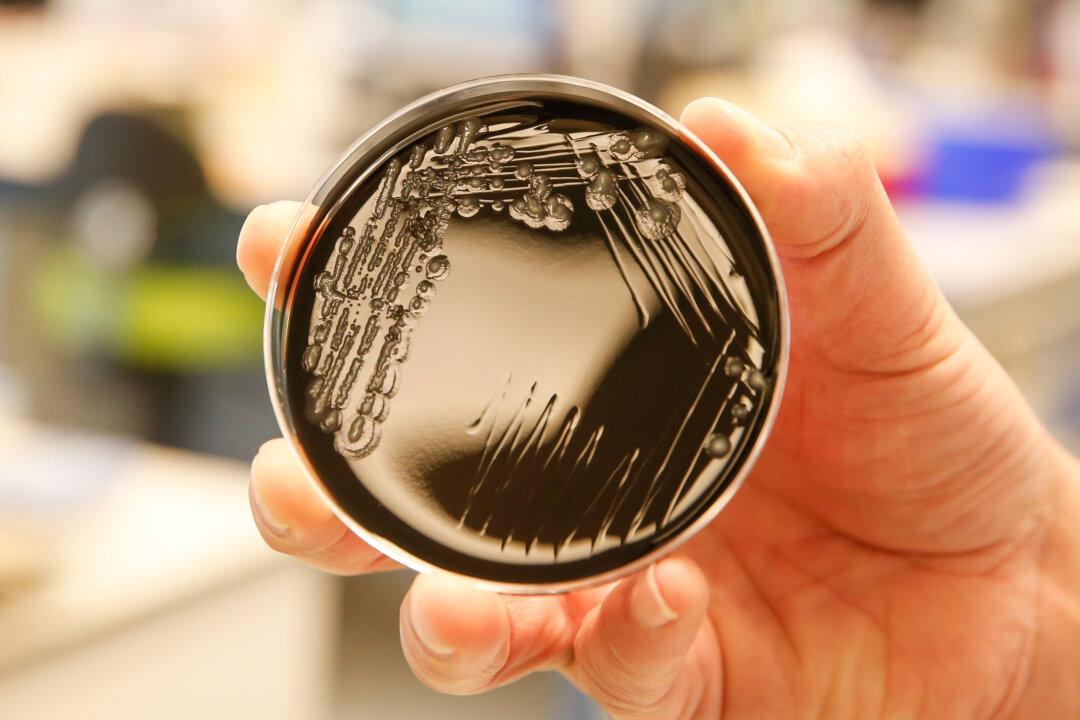

The Southern Nevada Health District (SNHD) said on Aug. 24 that it was investigating cases of Legionnaires’ disease—a severe form of pneumonia—among guests who stayed in two Las Vegas hotels between Aug. 1 and Aug. 23.
Two guests who stayed at Caesars Palace Hotel and Casino and one guest who stayed at The Orleans Hotel and Casino had been diagnosed with the disease, the health district stated in two separate releases.